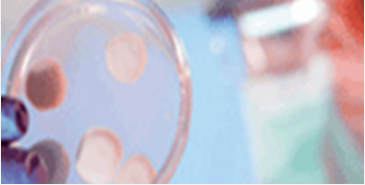

北京建都癫痫病医院 ・ 专注癫痫诊疗20年
北京建都癫痫病医院汇集知名神经医学专家,针对癫痫类型,病因及愈后进行科研及治疗,开展学术合作,保持医学水平前瞻性……[详情]

 北京非营利性医院
北京非营利性医院 北京医保定点医院
北京医保定点医院 中科院老专家科研基地
中科院老专家科研基地 儿童青少年特需门诊
儿童青少年特需门诊


名医汇聚 ・ 量身定制诊疗方案


资质
医师团队职称均在副主任医师以上

资历
临床癫痫诊疗经验均40年,康复者数万例

技术
分型分诊、规范化、从根源治疗癫痫病

学术
多次受邀参与权威研讨会及癫痫病交流会

学术聚焦 ・ 深入癫痫临床研究
多年来,北京建都癫痫病医院始终保持着与美国、英国等国际各大权威科研机构的合作,与美国疑难病研究协会成立国际精准诊疗医学联盟,为癫痫患者提供专业医学检查、联合会诊、临床诊疗、康复指导,全面提升了我国癫痫病诊疗水平。


公益典范 ・ 大医精诚实惠为民
北京建都癫痫病医院积极投身公益事业,足迹已遍全国30多个省市城乡,援助癫痫患者达数万人。为帮助更多家庭,多次走基层送医下乡,普及疾病知识,切实解决患者“看病贵,就医难”等问题,让更多久治不愈的癫痫患者看到康复希望!
北京建都医院
公益援助活动成果
北京建都医院
公益下乡义诊活动
北京建都医院
医疗志愿服务活动
北京建都医院
为震区捐款献爱心
北京建都癫痫病医院•专注专业治癫痫
非营利性专科医院
医院地址:北京市丰台区南三环赵公口桥南光彩路
健康咨询热线:010-58359967
本站信息仅做健康参考,具体诊疗请遵医师意见